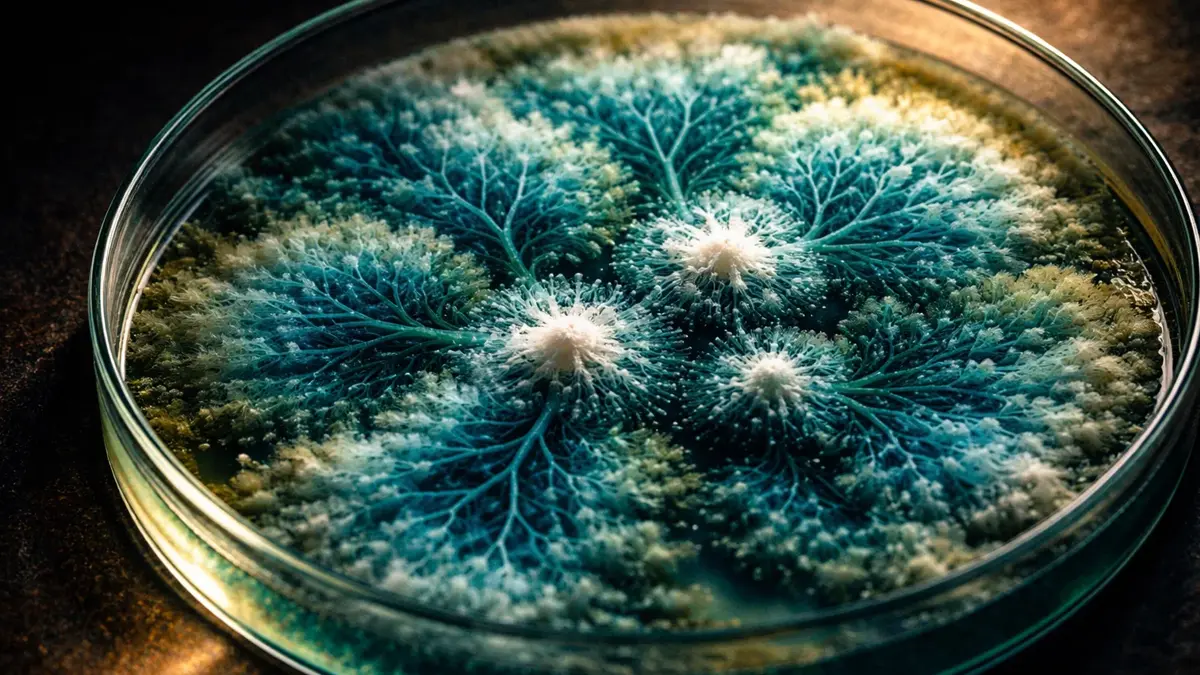
scoperte-scientifiche-casuali-serendipita-storia

L’immagine collettiva del ricercatore scientifico è spesso quella di una figura metodica, immersa in calcoli rigorosi e protocolli ferrei. Immaginiamo laboratori sterili dove ogni movimento è pianificato e ogni risultato è la logica conseguenza di anni di dedizione. Tuttavia, se osserviamo con attenzione la cronologia delle più grandi conquiste dell’umanità, emerge una verità tanto affascinante quanto umiliante: molte delle scoperte che hanno cambiato il corso della nostra specie sono nate da un errore, da una distrazione o da una coincidenza fortunata.
Questo fenomeno ha un nome preciso: serendipità. Non si tratta di semplice fortuna, ma della capacità di cogliere un valore inaspettato in un evento imprevisto. È il momento in cui il “fallimento” di un esperimento si rivela essere la porta d’accesso a un nuovo paradigma.
Il disordine che salvò milioni di vite
Il caso più celebre rimane, senza dubbio, quello di Alexander Fleming. Nel 1928, lo scienziato scozzese tornò dalle vacanze trovando il suo laboratorio in uno stato di relativo disordine. Una piastra di Petri contenente colture di stafilococco era stata lasciata esposta all’aria e contaminata da una muffa comune, il Penicillium notatum.
Invece di gettare semplicemente il campione contaminato, Fleming notò un dettaglio cruciale: attorno alla muffa, i batteri erano stati distrutti. Quello che per chiunque altro sarebbe stato un esperimento rovinato da scartare, per Fleming divenne l’intuizione della penicillina. Senza quel “disordine” iniziale e senza l’occhio attento di un uomo capace di leggere l’imprevisto, la medicina moderna non avrebbe mai avuto i suoi primi antibiotici, e milioni di infezioni oggi banali sarebbero ancora letali.
Dal freddo dello spazio al calore di casa
Il salto tecnologico non riguarda solo la biologia. Molti degli oggetti che oggi consideriamo scontati nelle nostre case sono figli del caso. Si pensi al forno a microonde. Nel 1945, Percy Spencer, un ingegnere della Raytheon che lavorava sui magnetron per i radar militari, si accorse che una barretta di cioccolato che teneva in tasca si era sciolta completamente mentre si trovava vicino all’apparecchiatura attiva.
Spencer non era lì per cucinare; era lì per potenziare i sistemi di difesa durante la guerra. Eppure, la sua curiosità lo spinse a testare altri alimenti, come i chicchi di mais (creando il primo popcorn da microonde della storia). Da una tecnologia progettata per intercettare bombardieri nemici nacque uno degli elettrodomestici più rivoluzionari del XX secolo.
La chimica dell’imprevisto: colori e materiali
Anche l’industria chimica e dei materiali è densa di questi momenti magici. Il Teflon, ad esempio, non fu il risultato di una ricerca su padelle antiaderenti. Nel 1938, Roy Plunkett stava cercando di creare un nuovo refrigerante. Un giorno, un campione di gas tetrafluoroetilene si polimerizzò spontaneamente all’interno di un contenitore, trasformandosi in una polvere bianca e scivolosa che non reagiva con nulla.
Allo stesso modo, la scoperta del colore “malva” da parte del giovanissimo William Perkin nel 1856 cambiò per sempre il mondo della moda e della chimica organica. Perkin stava cercando una sintesi artificiale del chinino per curare la malaria; ottenne invece un residuo scuro che, una volta sciolto in alcol, rivelò una tonalità di viola vibrante. Fu la nascita della prima tintura sintetica, in un’epoca in cui i colori per tessuti venivano ancora estratti faticosamente da piante e insetti.
Perché il caso ha bisogno di una mente pronta
Esiste un filo conduttore in tutte queste storie. Louis Pasteur diceva che “il caso favorisce solo la mente preparata”. La serendipità non è un evento passivo; richiede un osservatore che non si limiti a vedere, ma che sappia guardare.
Molti colleghi di Fleming avrebbero probabilmente buttato la piastra contaminata con fastidio. Molti ingegneri avrebbero maledetto la barretta di cioccolato sciolta che sporcava i pantaloni. La scoperta avviene quando l’anomalia viene trattata come un dato, non come un disturbo. È un esercizio di umiltà intellettuale: accettare che la natura abbia soluzioni più creative di quelle che abbiamo ipotizzato nei nostri piani di ricerca.

L’impatto sulla società contemporanea
Oggi viviamo in un’era dominata dai dati e dagli algoritmi. La ricerca è spesso guidata da obiettivi di mercato a breve termine o da protocolli di finanziamento estremamente rigidi che lasciano poco spazio alla deviazione. Tuttavia, l’importanza delle scoperte casuali solleva una questione fondamentale: stiamo lasciando abbastanza spazio all’imprevisto?
Se eliminiamo il margine d’errore, rischiamo di eliminare anche il margine d’innovazione. Molte delle sfide odierne — dalla crisi climatica alla ricerca di nuove fonti energetiche — potrebbero trovare soluzione non in ciò che stiamo cercando con ostinazione, ma in un effetto collaterale di un altro esperimento che stiamo conducendo proprio ora.
Scenario futuro: la serendipità artificiale
Con l’avvento dell’Intelligenza Artificiale, ci troviamo di fronte a un nuovo bivio. Le macchine sono programmate per l’ottimizzazione, non per l’errore. Eppure, alcuni ricercatori stanno iniziando a inserire “fattori di rumore” o elementi di casualità nei sistemi di apprendimento automatico proprio per simulare quel processo creativo che ha portato alla penicillina o al Teflon. L’obiettivo è creare una sorta di “serendipità computazionale”, dove l’IA possa suggerire connessioni tra campi del sapere apparentemente slegati, che un essere umano non prenderebbe mai in considerazione.
Oltre la superficie
Ripercorrere queste storie non è solo un esercizio di curiosità storica; è un modo per comprendere come funziona l’evoluzione della conoscenza. Ogni grande scoperta casuale apre una serie di domande sul rapporto tra metodo scientifico e intuizione pura.
Cosa sarebbe successo se quel giorno il laboratorio di Fleming fosse stato perfettamente pulito? Quanti altri “errori fortunati” stiamo ignorando perché troppo concentrati sull’obiettivo finale? Esplorare i dettagli tecnici e i contesti storici di questi momenti rivela una trama molto più complessa di quanto il termine “caso” possa suggerire. C’è un mondo sommerso di esperimenti falliti che hanno gettato le basi per la nostra modernità, e ognuno di essi merita di essere analizzato per capire dove stiamo andando.
Scarica la nostra app e ricevi notizie, curiosità, misteri, scoperte e tecnologia direttamente sul tuo smartphone.
Scarica per AndroidCuriosa per natura e appassionata di tutto ciò che è nuovo, Angela Gemito naviga tra le ultime notizie, le tendenze tecnologiche e le curiosità più affascinanti per offrirtele su questo sito. Preparati a scoprire il mondo con occhi nuovi, un articolo alla volta!






